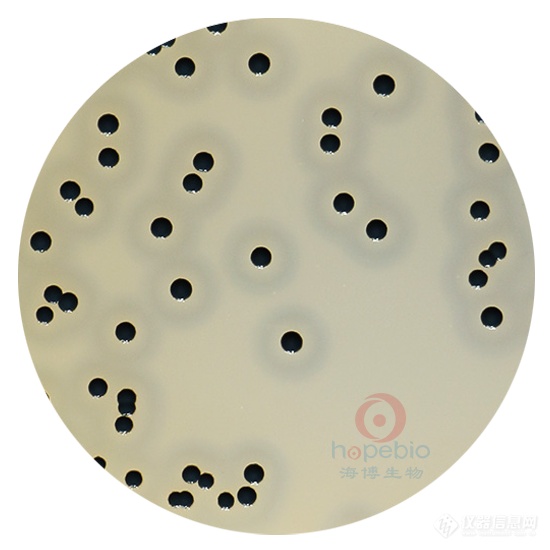
甘李药业公布国际专利申请：“一种选择性降解SMARCA2/4的化合物及其应用”

甘李药业公布国际专利申请:“一种选择性降解SMARCA2/4的化合物及其应用”

图片来源于网络,如有侵权,请联系删除
证券之星消息,根据企查查数据显示甘李药业(603087)公布了一项国际专利申请,专利名为“一种选择性降解SMARCA2/4的化合物及其应用”,专利申请号为PCT/CN2025/111639,国际公布日为2026年2月5日。
专利详情如下:
图片来源于网络,如有侵权,请联系删除
图片来源:世界知识产权组织(WIPO)
今年以来甘李药业已公布的国际专利申请3个。结合公司2025年中报财务数据,2025上半年公司在研发方面投入了2.65亿元,同比减0.73%。
数据来源:企查查
以上内容为证券之星据公开信息整理,由AI算法生成(网信算备310104345710301240019号),不构成投资建议。
目录 返回
首页
